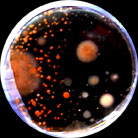
control at 4 ft

![]()
Summary of test results:
| Figure 1 Control (No treatment with air purifier) | ||
|---|---|---|

Plate A: Control 1 ft. |

Plate A: Control 2 ft. |
Plate A: Control 4 ft. |
Figure-1 shows the number of microbial colonies produced in the Control set, before any treatment of indoor air with the air purifier.
| Figure 3 (After 24 hr treatment with air purifier) | ||
|---|---|---|

Plate A: Control 1 ft. Plate A: 24 hr, 1 ft. |

Plate A: Control 2 ft. Plate A: 24 hr, 2 ft. |

Plate A: 24 hr, 4 ft. |
Figure 3 shows the petri-plates after a 24 hour treatment with the air purifier. Note the reduction in number of colonies compared to figure 1 (Control, No treatment with air purifier).
It was also evidenced that the petri-plates placed closer to the distance to the air purifier (1ft. and 2 ft.) produced least number of colonies after 24h., 48h. and 72 hours of treatment of the indoor air with the air purifier. Figure-3 shows the level of infection after 24 hours with distances 1 ft, 2ft. and 4 ft. away from the air purifier. There was very minor trace of inoculums from the petri-plates from 1 ft. or 2 ft. and 4 ft. distances after 24 hours of treatment of the room air indicating thereby definite reduction of the microbial aeroallergen in the room air. After 72 hours of treatment of the indoor air with the air purifier there was almost no micro flora or propagules left in the indoor air since there was no microbial colony produced on the petri-plates. All the experiments were carried out with setting at High in the air purifier. Figure 1 shows the Control plates without any treatment. All the 3 petri plates from the set up of 1ft, 2ft and 4 ft show vigorous growth of the microbial colonies after incubation in an incubator at 37 degrees Celsius.
Figure 1A
Number of microbial colonies produced
after 24 hours in Control (no Air Purifier)

Figure - 2
Effect of air purifier after different periods of exposure
on the number of microbial colonies.

From the figure-2 is a graph on the distribution of the number of microbial colonies before and after the treatment of indoor air with the air purifier, it is very clear that there was a gradual reduction in the number of microbial (bacterial and fungal) colonies with greater interval of exposure with the air purifier.
Figure - 3
Effect of treatment of air purifier on the concentration
of indoor aeroallergen concentration.

The petri plates from the set up of 24 hour treatment with air purifier from distances 1ft, 2ft and 4 ft from the air purifier showed no significant microbial growth. At the distance of 1 ft no microbial colony was recorded on the petri-plate while the petri plates from 2 and 4ft showed very minor trace of inoculums. Figure 4 shows the distribution of the aeroallergen count after the treatment of the room air after 24hour, 48 hour and 72 hours. After 72 hours of treatment there was almost no aeroallergen left closure to the air purifier.
View full abstract from West Texas A&M University, click here
The petri plates from the set up of 24 hour treatment with air purifier from distances 1ft, 2ft and 4 ft from the air purifier showed no significant microbial growth. At the distance of 1 ft no microbial colony was recorded on the petri-plate while the petri plates from 2 and 4ft showed very minor trace of inoculums. Figure 4 shows the distribution of the aeroallergen count after the treatment of the room air after 24hour, 48 hour and 72 hours. After 72 hours of treatment there was almost no aeroallergen left closure to the air purifier.
Find more information about testing conducted on Air Oasis air purifiers in the following publications:
Nabarun Ghosh, Mandy Whiteside and Dr. Jeff Bennert (2007). Reduction in indoor Aeroallergen by using a 3000 Air Purifier. Proceedings of World Allergy Congress, 2007 issue, Sweden.
Nabarun Ghosh, Jeff Bennert, Mandy Whiteside, Rupa Patel. (2007) Eradication of Indoor Aeroallergen Using a 3000 Air Purifier. Abstract Book, Plant Biology 2007, Chicago, Pg. 275.
Rupa Patel, Mandy Whiteside, Nabarum Ghosh and Jeff Bennert (2007). Qualitative Assay of Indoor Air Using a 3000 Air Purifier with Special Reference to the Reduction of Aero Allergens and Pollutants. Texas Journal of Microscopy, 38:1:53 (2007).
Choose from 7 air purifier models available online!
_20cm from top of unit_ _50cm from top of unit_
19 million (-) ions in 1 hour 19 million (-) ions in 1 hour
_ _
_Formaldehyde_
Start w/1.68mg/m3 after 24hr.- 0.85mg/m3 or approx. 60% reduction
_Bacteria_
Start 1920 cfu (colony forming units) after 1 hr. - 366cfu/m3 or an 80% reduction
Air Oasis 1000: production of negative ions was 18.7 million for 20cm and 18.1 million for 50cm.
Ozone production is .05ppm at 20cm and .01 ppm at 50cm. At 2ft. 0.00ppm
Children are more likely than adults to be affected by polluted indoor
air. They breathe faster, inhale more air per unit of body weight, and
are closer to the ground where concentrations are higher. (Department of
Consumer Affairs)

Documented by the Environmental Protection Agency as well as
countless scientific studies, indoor air pollution is one of
today's most common sources of toxins, bacteria, viruses,
particulates, mold and other fungi.
Most commercially purchased fiberglass filters are only 7%
efficient in stopping dirt, dust, pollen, etc. passing through
them. (American Society of Heating, Refrigeration, and Air Conditioning
Experts - ASHRAE)
All Air Oasis™ Air Purifiers come with a 3 year limited warranty.
All Air Oasis™ Air Purifiers have a 30 day money back Guarantee.
Order online or by phone.
Let our Air Purification Experts help you find the air purifier that is right for you.
800-570-9484

Dealer Inquiries Welcome.
FREE SHIPPING. You pay nothing for standard shipping in the United States. Questions about other rates or delivery times, contact us.

E-mail: via Contact form
Toll-free: 800-570-9484



